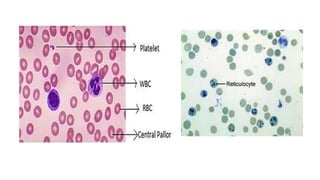

This document summarizes erythropoiesis, the production of red blood cells. It describes the stages of maturation from pluripotent stem cells to erythrocytes. Key stages include burst forming units and colony forming units that give rise to erythroblast precursors. Erythropoietin is the main growth factor that stimulates and regulates erythropoiesis. The bone marrow is typically the main site of erythropoiesis in adults, though the liver and spleen can also produce red blood cells early in development.





















![VARIATION IN SHAPE
• Crenation: [hypertonic solution].
• Spherocytosis: [hypotonic solution].
• Elliptocytosis: elliptical.
• Sickle cell: Crescentic shape
• Poikilocytosis: Presence of different
shaped cells [sickle cell anaemia].](https://image.slidesharecdn.com/doc-20230413-wa0013-230413045045-a42b2542/85/Haemopoesis-Erythropoesis-22-320.jpg)

![• Androgens - stimulate erythropoiesis. [Males - higher red cell count]
• Oestrogens - inhibits erythropoiesis by inhibiting erythropoietin production
and also by ↓ing the response of stem cells to erythropoietin.
• Thyroxin, Cortisol and Growth Hormone
1. Thyroxin stimulates erythropoiesis, it stimulates erythropoietin
production.
2. Growth hormone increases the mitosis and maturation of erythroid
precursors.
3. Cortisol produces mild erythrocytosis.](https://image.slidesharecdn.com/doc-20230413-wa0013-230413045045-a42b2542/85/Haemopoesis-Erythropoesis-58-320.jpg)


